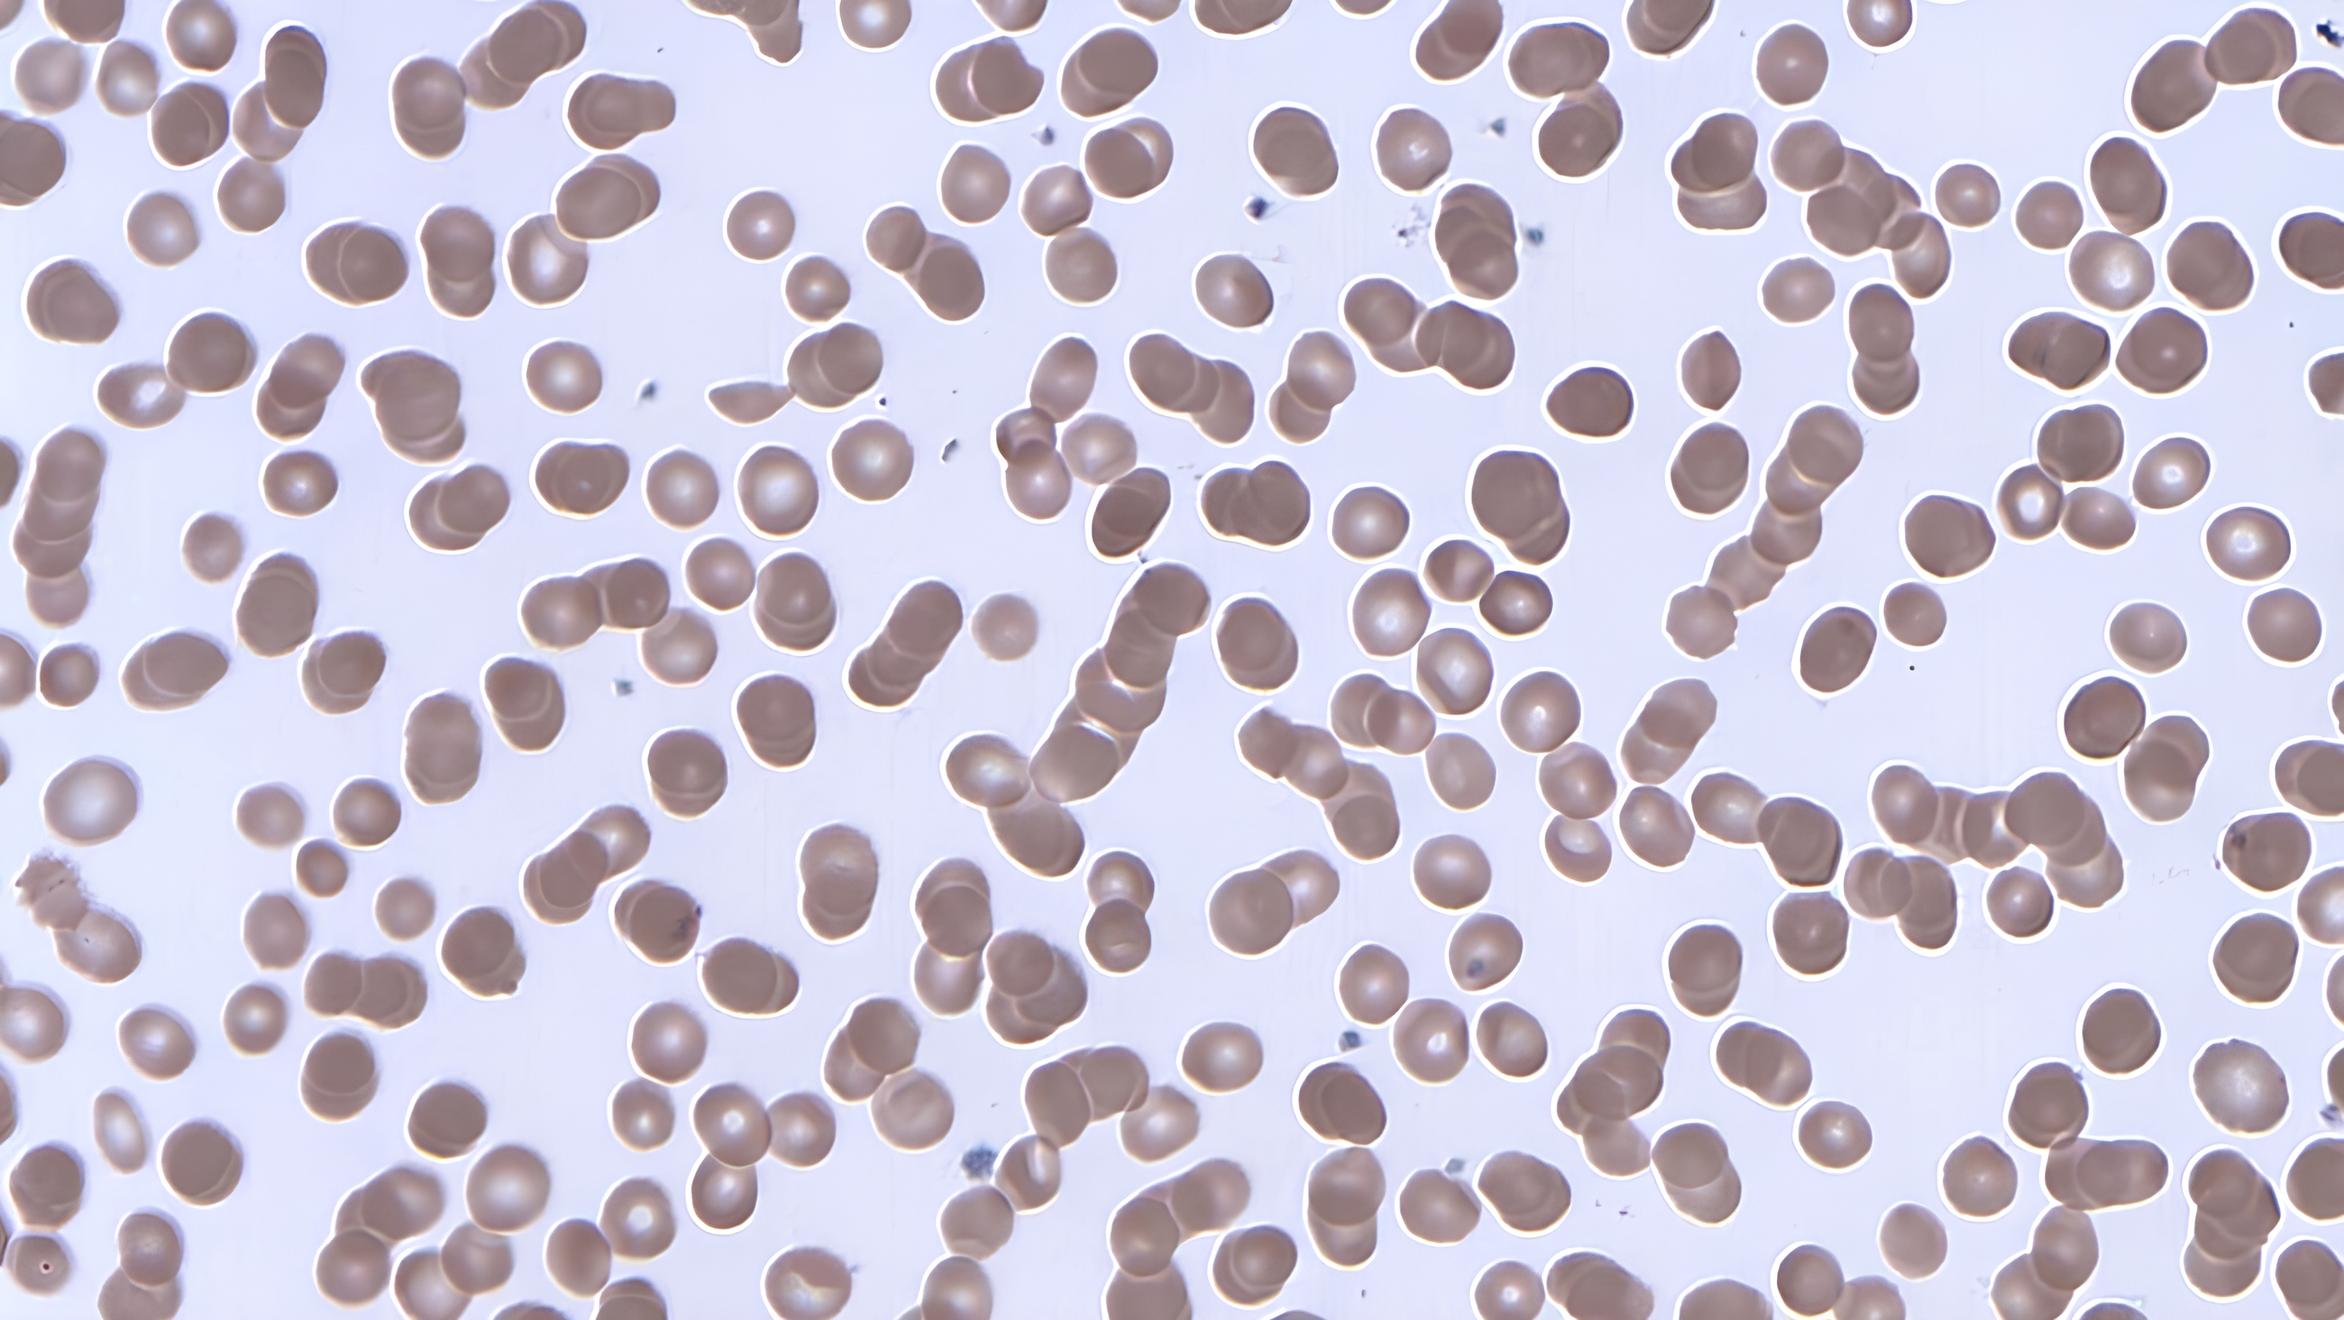
Smartphone có thể gây hại cho lưu thông máu? Nghiên cứu mới "gây tranh cãi" - Techlade

Khoa học
Bàn tay giả cảm nhận được nhiệt độ: Bước đột phá mới cho người khuyết tật
Các nhà nghiên cứu đã phát triển một bàn tay giả nhạy cảm với nhiệt độ, cho phép người khuyết chi cảm nhận được cả nóng và lạnh. “Chi ma” và giải pháp kích thích nhiệt Sau khi cắt cụt chi, nhiều người trải qua hiện tượng “chi ma“, nơi họ vẫn cảm thấy cảm […]
“Lưỡi điện tử” e-Taste: Công nghệ mô phỏng hương vị, bước tiến mới cho thực tế ảo
Các nhà nghiên cứu tại Đại học Bang Ohio đã phát triển một hệ thống có tên e-Taste, có khả năng mô phỏng hương vị của thực phẩm như bánh ngọt hay súp cá ngay trong miệng người dùng. Đây có thể là một bước tiến quan trọng giúp tái tạo trải nghiệm ăn uống […]
Liệu thời gian có thực sự chỉ chảy theo một hướng?
Chúng ta vẫn luôn mặc định rằng thời gian trôi theo một chiều từ quá khứ đến tương lai. Mỗi sáng, ta thức dậy, uống cà phê, lướt điện thoại và tiếp tục một ngày mới. Nhưng nếu thời gian không vận hành theo cách đó? Nếu sự tuyến tính của thời gian chỉ là […]
SpaceX được cấp phép bay lại Starship, tiếp tục cuộc đua chinh phục vũ trụ
Cơ quan Hàng không Liên bang Mỹ (FAA) vừa cấp phép cho SpaceX tiếp tục thử nghiệm Starship, bất chấp sự cố nổ tung trong chuyến bay thứ bảy vào tháng 1 vừa qua. Động thái này cho thấy tầm quan trọng của Starship trong chiến lược không gian của Mỹ và những ảnh hưởng […]
Smartphone có thể gây hại cho lưu thông máu? Nghiên cứu mới “gây tranh cãi”
Việc sử dụng smartphone có thể gây ra những ảnh hưởng tiêu cực đến lưu thông máu, theo một số nghiên cứu khoa học. Mới đây, một bài báo đã đưa ra cảnh báo về việc đặt điện thoại gần cơ thể có thể dẫn đến hình thành các cụm tế bào gọi là “rouleaux” […]
Atalante X: “Bộ giáp” robot giúp bệnh nhân đột quỵ “đi lại” sau 7 năm
Một nghiên cứu mới đã cho thấy kết quả khả quan trong việc sử dụng bộ khung xương ngoài Atalante X của Wandercraft để giúp một phụ nữ 64 tuổi bị liệt nửa thân trái sau đột quỵ 7 năm có thể đi lại tốt hơn sau một tháng điều trị. Theo CDC, đột quỵ […]
Não bộ “chiến thắng” nỗi sợ hãi: Phát hiện mới mở ra hy vọng cho người mắc chứng lo âu và PTSD
Các nhà khoa học vừa khám phá ra cách não bộ “vượt qua” nỗi sợ hãi bản năng, mở ra hy vọng cho các phương pháp điều trị mới dành cho người mắc chứng lo âu, rối loạn stress sau sang chấn (PTSD) và ám ảnh. Học cách “vượt qua” nỗi sợ Ngay từ khi […]
Samsung cập nhật Home Up, thỏa sức tùy chỉnh hiệu ứng
Samsung vừa phát hành bản cập nhật “lớn nhất từ trước đến nay” cho ứng dụng Home Up. Ứng dụng miễn phí này cho phép người dùng tùy chỉnh các hiệu ứng chuyển động của hệ thống theo nhiều cách khác nhau, nhưng hiện tại chỉ hỗ trợ One UI 7, tức là dành cho […]
Dữ liệu an toàn tuyệt đối: Freedom “bất khả xâm phạm” trên Mặt Trăng
Lonestar Data Holdings vừa hoàn thành thử nghiệm tích hợp trung tâm dữ liệu Freedom với tàu đổ bộ IM-2 Athena của Intuitive Machines, chuẩn bị cho sứ mệnh đưa trung tâm dữ liệu vật lý đầu tiên lên Mặt Trăng bằng tên lửa Falcon 9 của SpaceX trong quý 1/2025. Freedom: “Dự phòng dữ […]
Lemokey L5 HE 8K: Bàn phím cơ “siêu tốc” 8000Hz với switch từ tính
Lemokey, thương hiệu con của Keychron, vừa ra mắt bàn phím gaming L5 HE 8K với switch từ tính (Hall effect). Đây là bàn phím có dây với switch Lemokey Ultra-fast Lime Magnetic, tần số quét 8000Hz, giảm độ trễ xuống chỉ còn 0,125 mili giây. L5 HE 8K hỗ trợ điều chỉnh điểm kích […]